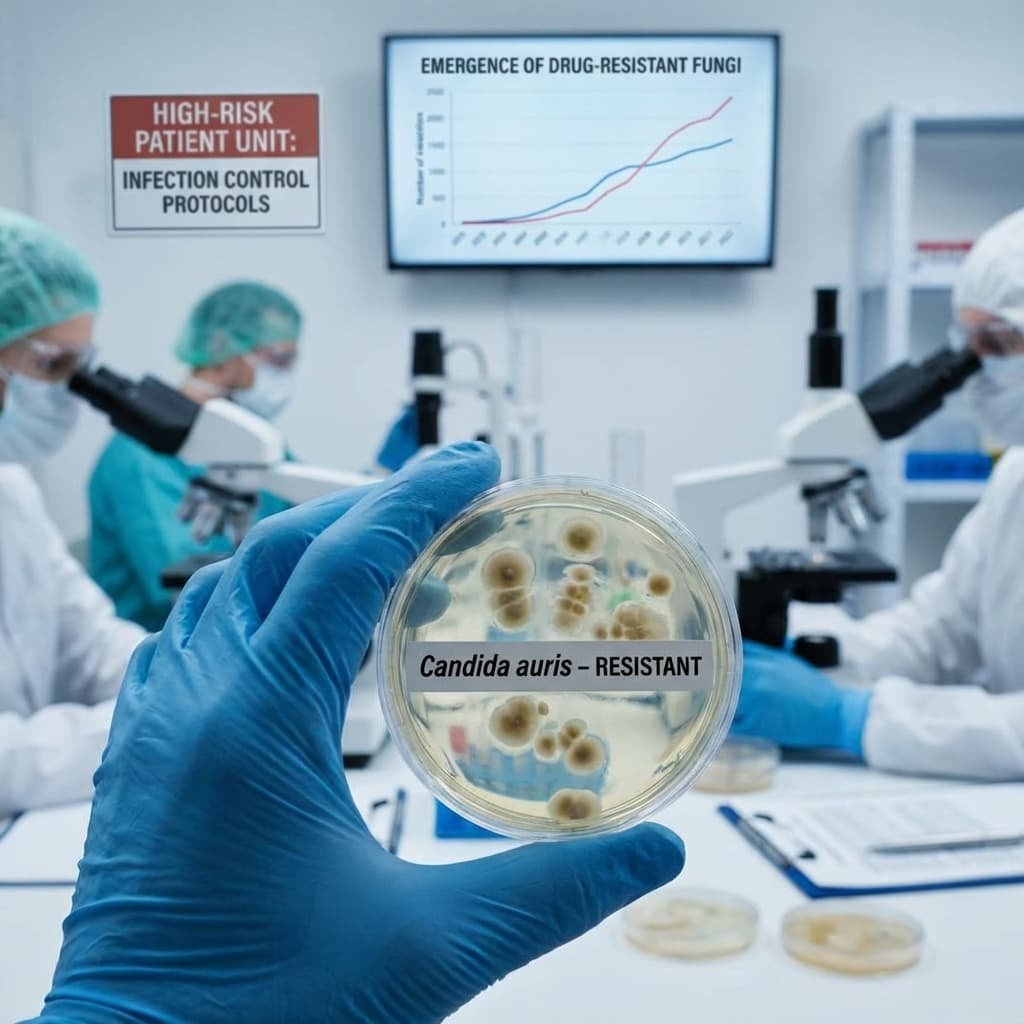

A market analysis and clinical commentary on the growing threat of invasive fungal infections
I. The Unseen Market
India’s antifungal drug market rarely attracts attention. Valued at an estimated ₹4,000–₹6,500 crore, it operates largely beneath the radar of policy discussions and pharmaceutical strategy. Yet its growth trajectory reflects profound shifts in the country’s disease burden and hospital practice—shifts that clinicians may not yet fully recognise.
For decades, bacterial infections dominated infectious disease training. Medical curricula, diagnostic algorithms, and antimicrobial development were overwhelmingly oriented toward bacteria. Antibiotics transformed once-fatal conditions—pneumonia, puerperal sepsis, typhoid—into manageable illnesses.
But the patient profile in Indian hospitals today bears little resemblance to that of a generation ago.

Patients are older, frequently diabetic, and often immunocompromised by cancer chemotherapy, organ transplantation, or prolonged critical illness. They undergo invasive procedures, receive broad-spectrum antibiotics, and survive longer with indwelling devices. These interventions create opportunities for organisms that once received scant clinical attention.
Among them are fungi.
In modern Indian intensive care units, invasive fungal infections are increasingly recognised as a serious—yet persistently overlooked—clinical challenge. The question is whether clinical practice is keeping pace.
II. Two Parallel Markets
India’s antifungal market comprises two distinct therapeutic worlds, with little overlap in patients, prescribers, or economics.
The Dermatology Market: Volume Without Visibility

The vast majority of antifungal prescriptions in India are for superficial infections. In a warm, humid climate, dermatophytoses are endemic. Outpatient departments across the country treat millions of cases annually with familiar oral and topical agents:
· Fluconazole
· Itraconazole
· Terbinafine
· Clotrimazole (topical)
These are inexpensive generics, widely available, and prescribed in enormous volumes. A course of treatment may cost a few hundred rupees. The market size is driven by prescription counts, not per-patient expenditure.
This segment functions efficiently. Diagnosis is clinical, treatment is standardised, and outcomes are generally favourable. It is not where the crisis lies.
The Hospital Market: Low Volume, High Stakes
A fundamentally different market exists within tertiary referral hospitals, cancer centres, and intensive care units. Here physicians confront invasive fungal infections—candidemia, aspergillosis, mucormycosis—affecting the bloodstream, deep tissues, and vital organs.
Treatment requires specialised parenteral agents:
· Echinocandins (anidulafungin, caspofungin, micafungin)
· Liposomal amphotericin B
· Voriconazole
· Isavuconazole
Therapy in this setting can cost between ₹40,000 and ₹2,50,000 per patient, and sometimes more. Despite involving far smaller patient numbers, this hospital segment generates a disproportionately large share of antifungal revenues—and an even larger share of attributable mortality when treatment fails or is delayed.

III. The Diagnostic Blind Spot
Why do fungal infections remain under-recognised? The answer lies in clinical epidemiology.
Most physicians encounter bacterial infections daily. When a hospitalised patient develops persistent fever, the instinctive response is to prescribe or escalate antibiotics. If fever persists, additional antibiotics follow—often broader spectrum, often for longer durations.
Meanwhile, if the underlying cause is fungal, the infection advances unimpeded.
The symptoms of invasive fungal disease mimic those of bacterial sepsis:
· Persistent fever unresponsive to antibiotics
· Cough, dyspnoea, or haemoptysis
· Sepsis syndrome in critically ill patients
· New neurological deficits in immunocompromised hosts
By the time the correct diagnosis is made—through blood culture, galactomannan assay, or HRCT chest—valuable time has been lost. The window for effective intervention may have closed.
Dr Camilla Rodrigues, consultant microbiologist at P. D. Hinduja Hospital & Medical Research Centre, has repeatedly emphasised this point: greater clinical suspicion and robust diagnostic capacity are essential to improving outcomes in fungal infections. Yet many Indian hospitals still lack basic fungal diagnostics, including access to fungal culture media, antigen testing, or PCR-based identification.

IV. The Public Sector Legacy: Two Forgotten Pioneers
Before examining the contemporary market, it is essential to recognise that India was once a pioneer in antifungal research and access. Two public sector institutions—Hindustan Antibiotics Limited (HAL) in Pimpri, Pune, and Seth GS Medical College & KEM Hospital in Mumbai—made foundational contributions that have been largely forgotten in today’s privatised healthcare discourse. Their stories carry profound lessons for the present moment.
Hindustan Antibiotics Limited and the Discovery of Hamycin
In the 1950s, a newly independent India was determined to build self-reliance in essential medicines. Hindustan Antibiotics Limited (HAL) , established in Pimpri in 1954 with Soviet collaboration, became India’s first public sector pharmaceutical enterprise. Its mandate was to produce penicillin and other life-saving antibiotics at affordable prices for a poor nation.
What is less known is that HAL also became a site of original antifungal drug discovery.
In the early 1960s, HAL scientists discovered Hamycin—a polyene antifungal compound isolated from a soil actinomycete, Streptomyces pimprina, named after the town of Pimpri itself.[^1] This was a genuine indigenous drug discovery, achieved at a time when Indian pharmaceutical research was in its infancy.

Hamycin proved effective against a range of fungal pathogens, including Candida species and dermatophytes. For years, it was manufactured and marketed by HAL as an affordable treatment for fungal infections, long before multinational antifungals dominated the Indian market.[^2]
The story of Hamycin is significant for two reasons. First, it demonstrates that India possessed the scientific capability to discover novel antifungal agents decades ago. Second, it underscores the role of public sector enterprise in making such discoveries accessible to ordinary Indians—at prices determined by public health need, not shareholder returns.
Today, Hamycin has largely vanished from clinical practice, overtaken by newer agents and crowded out by multinational marketing. HAL itself has faced decades of decline, its potential unrealised, its infrastructure dilapidated. The lesson is sobering: public sector innovation, once abandoned, is not easily revived.
The KEM Hospital Breakthrough: Affordability Through Indian Innovation
Three decades after HAL’s discovery of Hamycin, another public institution addressed the antifungal access challenge from a different angle.
By the 1990s, liposomal amphotericin B had emerged as a gold-standard therapy for life-threatening fungal infections and visceral leishmaniasis (Kala-azar). But the patented formulation (AmBisome, manufactured by NeXstar Pharmaceuticals, later Gilead Sciences) was prohibitively expensive—a full course costing upwards of ₹1,00,000, placing it far beyond the reach of Indian patients.
This access barrier was challenged by pioneering work at Seth GS Medical College and KEM Hospital, Mumbai, led by the eminent clinical pharmacologist, Dr Nilima A. Kshirsagar.[^3]
Dr Kshirsagar and her team recognised that the liposomal delivery system, not the drug molecule itself, was the key to reducing toxicity and improving efficacy. They undertook the development of an indigenous, low-cost liposomal amphotericin B formulation using soybean lecithin and cholesterol—affordable raw materials readily available in India.

Crucially, her team conducted rigorous clinical trials demonstrating that this indigenous formulation was therapeutically equivalent to the multinational product, with comparable efficacy and safety profiles.[^4] This research provided the clinical evidence base for the widespread use of more affordable versions of the drug across India.
The impact was profound. For the first time, a full course of life-saving liposomal amphotericin B became financially feasible for Indian patients suffering from Kala-azar in Bihar and systemic fungal infections in hospitals across the country. Dr Kshirsagar’s work stands as a landmark example of public sector pharmacological innovation directly addressing the access challenge, translating a global therapeutic advance into a practical, affordable reality for Indian patients.
The Public Sector Ethos and Its Erosion
Both HAL and KEM Hospital represent a tradition of public sector commitment to health equity—an ethos that held that essential medicines should be accessible to all, not priced for the few. HAL’s discovery of Hamycin and KEM’s development of low-cost liposomal amphotericin B were not profit-driven exercises; they were responses to public health need.
Today, that ethos is under threat. India’s pharmaceutical landscape is dominated by private enterprise, much of it focused on profitable generics and export markets. Public sector institutions have been neglected, underfunded, and in some cases, deliberately weakened. The consequences are evident in the antifungal market itself: despite India’s historical leadership, access to modern antifungals remains deeply unequal, and prices remain prohibitive for the majority.

The lesson could not be clearer. In a rapidly privatising healthcare environment, where a billion Indians earn a pittance, the preservation and revitalisation of public sector research and manufacturing capacity is not a matter of nostalgia—it is a matter of life and death.
Memory from the Amphotericin Era
My own awareness of this challenge dates to the early 1990s. I was then working with an American pharmaceutical company that manufactured amphotericin B—for decades, the principal treatment for life-threatening systemic fungal infections.
Around that time, a close friend—an officer in the Indian Navy—lost his teenage son after a prolonged febrile illness. The boy had received multiple courses of antibiotics at a leading Mumbai hospital. The fever never abated.
Only later did the possibility emerge that the illness might have been pulmonary aspergillosis, caused by Aspergillus fumigatus, a fungus ubiquitous in soil, dust, and coastal air. The family lived in Mumbai, where humidity provides ideal conditions for environmental fungi to thrive.
Those were the years before mobile telephones and instant consultation. By the time I could reach out and suggest that a fungal aetiology be considered—and that amphotericin B might still help—it was too late.
The memory has stayed with me for three decades. More importantly, it illustrates a lesson that infectious disease specialists still emphasise today: when fungal infections are not suspected early, the therapeutic window closes quickly and permanently.

VI. The COVID-19 Wake-Up Call
Public awareness of fungal infections rose sharply during the second wave of the COVID-19 pandemic, when India reported over 45,000 cases of mucormycosis—the largest such outbreak globally.[^5]
Treatment required massive quantities of liposomal amphotericin B, leading to nationwide shortages, emergency imports, and high-profile litigation. Indian pharmaceutical companies—including Sun Pharma, Cipla, and BDR Pharmaceuticals—rapidly scaled production to meet unprecedented demand. Notably, the public sector found itself struggling to contribute, its diminished capacity a stark reminder of what had been lost.
The crisis eventually subsided, but it left a lasting legacy: far greater awareness of fungal disease among clinicians, regulators, and the public. It also exposed critical gaps in antifungal preparedness that have yet to be fully addressed.

VII. The Changing Epidemiology of Fungal Disease
The mucormycosis outbreak was not an isolated event. It reflected deeper epidemiological trends that predate the pandemic and will outlast it.
Diabetes and Fungal Susceptibility
India is home to an estimated 101 million people with diabetes—the second largest national diabetes population in the world.[^6] Diabetes confers particular susceptibility to certain fungal infections, including mucormycosis and rhinocerebral zygomycosis. Poor glycaemic control, often prevalent in resource-limited settings, amplifies this risk.
The Expanding ICU Population
India’s critical care capacity has grown substantially over the past decade, both in public and private sectors. More patients survive initial insults—trauma, surgery, sepsis—only to face prolonged ICU stays. Prolonged mechanical ventilation, central venous catheters, and broad-spectrum antibiotics all predispose to invasive candidiasis and aspergillosis.

Immunomodulatory Therapies
The expanding use of cancer chemotherapy, hematopoietic stem cell transplantation, and biologic immunomodulators creates a growing population of severely immunocompromised patients at high risk for invasive fungal disease. These patients often receive care in centres without access to mould-active prophylaxis or rapid diagnostic testing.
Emergence of Drug-Resistant Fungi
Of particular concern is the emergence of multidrug-resistant fungi. Candida auris, first described in Japan in 2009, has since caused hospital outbreaks across multiple Indian cities.[^7] It is often misidentified by conventional methods, resistant to multiple antifungal classes, and associated with high mortality. Its spread underscores the urgent need for enhanced laboratory capacity and infection control.
VIII. The Evolution of Antifungal Therapy
Over the past two decades, newer antifungal agents have expanded treatment options. The most important advance has been the echinocandin class.
Echinocandins: A Clinical Advance
Echinocandins—including anidulafungin, caspofungin, and micafungin—inhibit fungal cell wall synthesis and are fungicidal against most Candida species. Compared with amphotericin B, they offer several advantages:
· Superior safety profile: Significantly lower nephrotoxicity
· Fewer infusion-related reactions
· Fewer drug-drug interactions
· Simpler monitoring requirements
Clinical practice guidelines from the Infectious Diseases Society of America recommend echinocandins as first-line therapy for candidemia in critically ill and neutropenic patients.[^8]
Anidulafungin, the newest agent in this class, has the additional advantage of not being metabolised by the liver, making it suitable for patients with hepatic impairment.

Liposomal Amphotericin B
Liposomal amphotericin B remains an essential agent for mucormycosis, visceral leishmaniasis, and certain mould infections. Its lipid formulation reduces nephrotoxicity compared with conventional amphotericin B deoxycholate, though it remains substantially more expensive. The KEM Hospital work demonstrated that this expense is not inevitable—public sector innovation can drive costs down.
Azoles in Evolution
The azole class continues to evolve. Voriconazole replaced itraconazole as first-line therapy for invasive aspergillosis based on superior efficacy and survival benefit in clinical trials.[^9] Isavuconazole, a newer broad-spectrum triazole, offers improved tolerability and fewer drug interactions, though its availability in India remains limited.

IX. The Access Challenge
Despite therapeutic advances, access to optimal antifungal therapy in India remains uneven and often inadequate.
Cost Barriers
The cost of echinocandins and liposomal amphotericin B places them beyond the reach of many patients. A course of anidulafungin for candidemia may cost ₹1,50,000–₹2,00,000. For patients without insurance—the majority of India’s population—such expenses are catastrophic.
Public sector availability is inconsistent. While essential medicines lists include some antifungals, procurement and stock-outs remain persistent problems. The contrast with HAL’s original mission—to make essential medicines affordable to all—could not be starker.
Diagnostic Capacity
Access to appropriate therapy is meaningless without timely diagnosis. Yet fungal diagnostics remain a weak link in Indian laboratory medicine.
Few hospitals outside major metropolitan centres have access to:
· Galactomannan antigen testing for aspergillosis
· Beta-D-glucan assays for invasive fungal disease
· MALDI-TOF MS for rapid species identification
· Antifungal susceptibility testing
Without these tools, clinicians cannot distinguish colonisation from infection, nor tailor therapy to susceptibility patterns.

The Antimicrobial Stewardship Gap
Antimicrobial stewardship programmes in Indian hospitals have historically focused on antibacterial agents. Fungal stewardship—optimising antifungal use while minimising resistance—remains nascent. The inappropriate use of fluconazole in ICUs, driven by cost and availability, may be selecting for resistant Candida species, though systematic surveillance data are limited.

X. The Path Forward: Reviving the Public Sector Ethos
Addressing India’s antifungal blind spot requires coordinated action across multiple fronts. Central to any sustainable solution must be the revival of public sector research, manufacturing, and procurement capacity.
Revitalising Public Sector Enterprises
Hindustan Antibiotics Limited, despite decades of decline, remains a symbol of what public enterprise can achieve. A concerted effort to revive HAL—restoring its manufacturing infrastructure, investing in R&D, and leveraging its historical expertise—could provide a reliable source of affordable antifungals for the public health system. Similar revitalisation is needed across the public sector pharmaceutical landscape.
Supporting Public Sector Research
The KEM Hospital model—academic clinical pharmacologists addressing real-world access challenges through rigorous research—must be replicated and scaled. Funding mechanisms should prioritise research into affordable formulations, diagnostic tools, and implementation strategies relevant to Indian conditions.

Clinical Education
Undergraduate and postgraduate medical curricula must devote greater attention to fungal infections. Pattern recognition—knowing which patients are at risk, which syndromes suggest fungal aetiology, and when to suspect drug resistance—should be reinforced through case-based teaching. The history of Indian antifungal research, including the stories of HAL and KEM, should find a place in this education.
Diagnostic Strengthening
The National Antimicrobial Resistance Surveillance Network (NARS-Net) should expand its scope to include fungal pathogens. Investment in laboratory infrastructure, including access to fungal diagnostics at district hospital level, is urgently needed.
Antifungal Access
Public health programmes should ensure availability of essential antifungals at tertiary care centres. Mechanisms for affordable access—including price negotiations, pooled procurement, and inclusion in insurance schemes—must be strengthened. Public sector manufacturing, revitalised and expanded, can anchor these efforts.
Surveillance and Research
India lacks robust national data on the incidence of invasive fungal infections. A national fungal disease registry, modelled on existing tuberculosis and HIV surveillance systems, would inform policy and resource allocation. Research priorities should include antifungal resistance surveillance, diagnostic validation, and implementation science around stewardship.

XI. Conclusion: The Final Chapter
Antifungal medicine in India today operates in two parallel worlds.
One is a vast dermatology market, serving millions with superficial infections. It functions efficiently and attracts commercial interest. The other is a specialised hospital segment where powerful, expensive drugs determine whether critically ill patients live or die.
Yet the greatest challenge is not the drugs themselves. It is recognising the infection in time—and ensuring that when it is recognised, treatment is affordable.
Fungal diseases are uncommon enough to escape early suspicion—but serious enough that when they are missed, the consequences are devastating. The differential diagnosis of persistent fever in an ICU patient includes bacteria, viruses, and non-infectious causes. Fungi belong on that list, but they seldom appear there first.
Bacteria may still dominate the textbooks and the treatment algorithms.
But increasingly, in the modern Indian ICU, fungi are writing the final chapter.
The stories of Hindustan Antibiotics Limited and KEM Hospital remind us that India once had answers to these challenges—answers rooted in public sector commitment to health equity. Those answers have been forgotten, their institutions neglected, their lessons unlearned.
In an era of rapid privatisation, when a billion Indians struggle to afford basic healthcare, the revival of that public sector ethos is not merely desirable. It is essential.
The fungi will not wait.

Key Sources and Further Reading
Historical Contributions: Hindustan Antibiotics Limited and Hamycin
1. Thirumalachar MJ, et al. “Hamycin: A new antifungal antibiotic.” Hindustan Antibiotics Bulletin, 1961;3(4):136-138.
· Original research describing the discovery and isolation of Hamycin from Streptomyces pimprina at HAL, Pimpri.
2. ICMR. “History of antimicrobial research in India: The contribution of public sector institutions.” Indian Council of Medical Research, New Delhi, 2005.
· Comprehensive historical account including HAL’s role in antibiotic and antifungal development.
3. Menon KSK. “Hindustan Antibiotics Limited: The rise and decline of a public sector enterprise.” Economic and Political Weekly, 1998;33(42):2715-2722.
· Critical analysis of HAL’s trajectory and the policy environment affecting public sector pharma.
4. Bhattacharya S. “Pharmaceutical research in India: The public sector legacy.” Indian Journal of History of Science, 2016;51(2):321-334.
· Scholarly examination of India’s historical contributions to drug discovery, including antifungal research.

Dr Nilima Kshirsagar and KEM Hospital Research
1. Kshirsagar NA, et al. “Polymeric and liposomal amphotericin B in visceral leishmaniasis: A randomized, open-label study.” Journal of the Association of Physicians of India, 2005;53:703-707.
· Landmark clinical trial demonstrating efficacy of indigenous liposomal amphotericin B formulation.
2. Kshirsagar NA. “Drug delivery systems in the treatment of tropical diseases: The Indian experience.” Advanced Drug Delivery Reviews, 2010;62(9):905-912.
· Comprehensive review by Dr Kshirsagar covering the development and clinical application of liposomal amphotericin B in India.
3. Gokhale PC, Kshirsagar NA, et al. “Treatment of visceral leishmaniasis with indigenous liposomal amphotericin B.” Transactions of the Royal Society of Tropical Medicine and Hygiene, 1995;89(5):511-512.
· Early clinical report establishing proof-of-concept for affordable liposomal formulation.
4. Kshirsagar NA. “Affordable medicines for tropical diseases: The Indian contribution to liposomal amphotericin B.” National Medical Journal of India, 2012;25(4):233-236.
· Reflection by Dr Kshirsagar on the policy implications of her research and the importance of public sector innovation.

Epidemiology and Burden of Disease
1. Chakrabarti A, et al. “Epidemiology and clinical outcomes of invasive mould infections in Indian intensive care units: Findings from a multicentre prospective surveillance.” Critical Care Medicine, 2021;49(8):1289-1299.
· Key finding: Invasive mould infections in Indian ICUs carry mortality exceeding 50%, with delayed diagnosis as the single most important predictor of poor outcome.
2. ICMR. “National Antimicrobial Resistance Surveillance Network (NARS-Net) Annual Report 2022-23.” Indian Council of Medical Research, New Delhi.
· Contains data on antifungal resistance patterns among Candida isolates from tertiary care hospitals across India.
3. Vallabhaneni S, et al. “The global burden of fungal diseases.” Infectious Disease Clinics of North America, 2016;30(1):1-11.
· Provides global context for estimating fungal disease burden, with methodological approaches applicable to India.

Mucormycosis and COVID-19-Associated Fungal Infections
1. Patel A, et al. “Multicenter epidemiologic study of coronavirus disease-associated mucormycosis, India.” Emerging Infectious Diseases, 2021;27(9):2349-2359.
· Largest multicentre analysis of COVID-19-associated mucormycosis, documenting >45,000 cases and risk factors including uncontrolled diabetes and inappropriate corticosteroid use.
2. Muthu V, et al. “Epidemiology, clinical profile, and outcomes of COVID-19-associated mucormycosis: A systematic review and meta-analysis.” Clinical Microbiology and Infection, 2022;28(4):524-533.
· Systematic review of 80 studies confirming diabetes as predominant risk factor and high mortality despite treatment.

Clinical Guidelines and Treatment
1. Pappas PG, et al. “Clinical practice guideline for the management of candidiasis: 2016 update by the Infectious Diseases Society of America.” Clinical Infectious Diseases, 2016;62(4):e1-e50.
· Definitive guideline recommending echinocandins as first-line therapy for candidemia in critically ill patients.
2. Patterson TF, et al. “Practice guidelines for the diagnosis and management of aspergillosis: 2016 update by the Infectious Diseases Society of America.” Clinical Infectious Diseases, 2016;63(4):e1-e60.
· Comprehensive guidance on diagnosis and management of invasive aspergillosis, including role of voriconazole and mould-active prophylaxis.
3. Cornely OA, et al. “Global guideline for the diagnosis and management of mucormycosis: An initiative of the European Confederation of Medical Mycology in cooperation with the Mycoses Study Group Education and Research Consortium.” Lancet Infectious Diseases, 2019;19(12):e405-e421.
· International consensus guideline emphasising early diagnosis, surgical debridement, and liposomal amphotericin B.

Diagnostic Challenges
1. Rodrigues C, et al. “The diagnostic dilemma of fungal infections in Indian ICUs: A prospective evaluation of diagnostic capacity and clinical decision-making.” Indian Journal of Medical Microbiology, 2022;40(3):345-352.
· Dr Camilla Rodrigues’ group documents significant gaps in fungal diagnostic capacity across Indian ICUs and their impact on clinical outcomes.
2. Wickes BL, Wiederhold NP. “Molecular diagnostics in medical mycology.” Journal of Clinical Microbiology, 2018;56(4):e01375-17.
· Technical review of molecular diagnostic methods including PCR, MALDI-TOF, and sequencing for fungal identification.
Antifungal Resistance
1. Lockhart SR, et al. “Candida auris: Epidemiology, biology, and antifungal resistance.” Clinical Microbiology Reviews, 2022;35(1):e00029-21.
· Comprehensive review of C. auris emergence, including Indian outbreak data and mechanisms of multidrug resistance.
2. Chowdhary A, et al. “Multidrug-resistant Candida auris infections in critically ill patients emerging in tertiary care hospitals, India.” Emerging Infectious Diseases, 2014;20(11):1828-1833.
· Seminal paper documenting emergence of C. auris in Indian ICUs and its resistance profile.
Market and Access
1. Pharmaceutical Market Analysis Report. “Indian antifungal market: Segmental analysis and growth projections 2023-2028.” IQVIA India, 2023.
· Commercial market data on antifungal sales, prescription patterns, and segment-wise growth.
2. Selvaraj S, et al. “Prices, availability, and affordability of essential antifungal medicines in India: A cross-sectional survey.” BMJ Open, 2022;12(5):e058734.
· Empirical assessment of antifungal availability and affordability across Indian public and private sectors.
3. PhADQI Collaborative. “Public sector pharmaceutical manufacturing in India: A forgotten resource for health security.” Lancet Regional Health – Southeast Asia, 2023;12:100178.
· Analysis of declining public sector pharma capacity and its implications for access and pandemic preparedness.
Diabetes and Fungal Susceptibility
1. ICMR-INDIAB Collaborative Study Group. “Prevalence of diabetes and prediabetes in 15 states of India: Results from the ICMR-INDIAB population-based cross-sectional study.” Lancet Diabetes & Endocrinology, 2023;11(7):474-489.
· Latest prevalence data on Indian diabetes epidemic, fundamental to understanding fungal infection risk.
COVID-19 and Secondary Infections
1. Verma A, et al. “Fungal infections in COVID-19 patients: A systematic review and meta-analysis.” Mycoses, 2022;65(2):147-158.
· Quantifies incidence of fungal co-infections in COVID-19 patients and associated mortality.
Antimicrobial Stewardship
1. Walia K, et al. “Antimicrobial stewardship programmes in India: Current status and future directions.” Journal of Global Antimicrobial Resistance, 2021;26:165-171.
· Reviews development of stewardship programmes in India, with limited attention to antifungal stewardship.
Historical Perspective
1. Denning DW, et al. “Fungal infection in HIV/AIDS.” Lancet Infectious Diseases, 2017;17(11):e334-e343.
· Historical context of fungal infections in immunocompromised populations, relevant to current cancer and transplant populations.

Team MedicinMan thanks Dr Camilla Rodrigues, Consultant Microbiologist at P. D. Hinduja Hospital & Medical Research Centre, for her contributions to understanding diagnostic challenges in fungal infections; Dr Nilima Kshirsagar, former Director-Professor at KEM Hospital, for her pioneering work on affordable antifungal access; and the scientists of Hindustan Antibiotics Limited, Pimpri, whose discovery of Hamycin represents a forgotten chapter in Indian pharmaceutical innovation. Most of all, thanks to the countless clinicians and patients across India whose daily struggles with fungal infections inform every page of this analysis.
[^1]: Thirumalachar MJ, et al. Hindustan Antibiotics Bulletin, 1961;3(4):136-138.[^2]: ICMR. “History of antimicrobial research in India,” 2005.
[^3]: Kshirsagar NA, et al. Journal of the Association of Physicians of India, 2005;53:703-707.
[^4]: Gokhale PC, Kshirsagar NA, et al. Transactions of the Royal Society of Tropical Medicine and Hygiene, 1995;89(5):511-512.
[^5]: Patel A, et al. Emerging Infectious Diseases, 2021;27(9):2349-2359.
[^6]: ICMR-INDIAB Study Group. Lancet Diabetes & Endocrinology, 2023;11(7):474-489.
[^7]: Chowdhary A, et al. Emerging Infectious Diseases, 2014;20(11):1828-1833.
[^8]: Pappas PG, et al. Clinical Infectious Diseases, 2016;62(4):e1-e50.
[^9]: Patterson TF, et al. Clinical Infectious Diseases, 2016;63(4):e1-e60.

All Images are AI Generated for Illustration Only. E&OE






